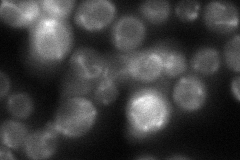

View description
Mitochondrial alcohol dehydrogenase isozyme III; involved in the shuttling of mitochondrial NADH to the cytosol under anaerobic conditions and ethanol production
Localization:
Intensity:
Fold change:
Significance:
-
C’ GFP library in SD

mitochondria120.86 -
N' NOP1pr-GFP in SD

mitochondria143.437 -
N' TEF2pr-mCherry in SD

mitochondria330.976 -
N' NATIVEpr-GFP in SD
ER,mitochondria51.9776 -
N' TEF2pr-VC and Cyto-VN in SD

#N/A0 -
C’ GFP library in SD+DTT

mitochondria139.861.15No -
C’ GFP library in SD+H2O2

mitochondria84.030.69No -
C’ GFP library in Starvation Media

mitochondria180.381.49Yes -
C’ GFP library on the background of Pup2-DaMP

mitochondria -
C’ GFP library on the background of CCT mutant

mitochondria133.4121.10378No
